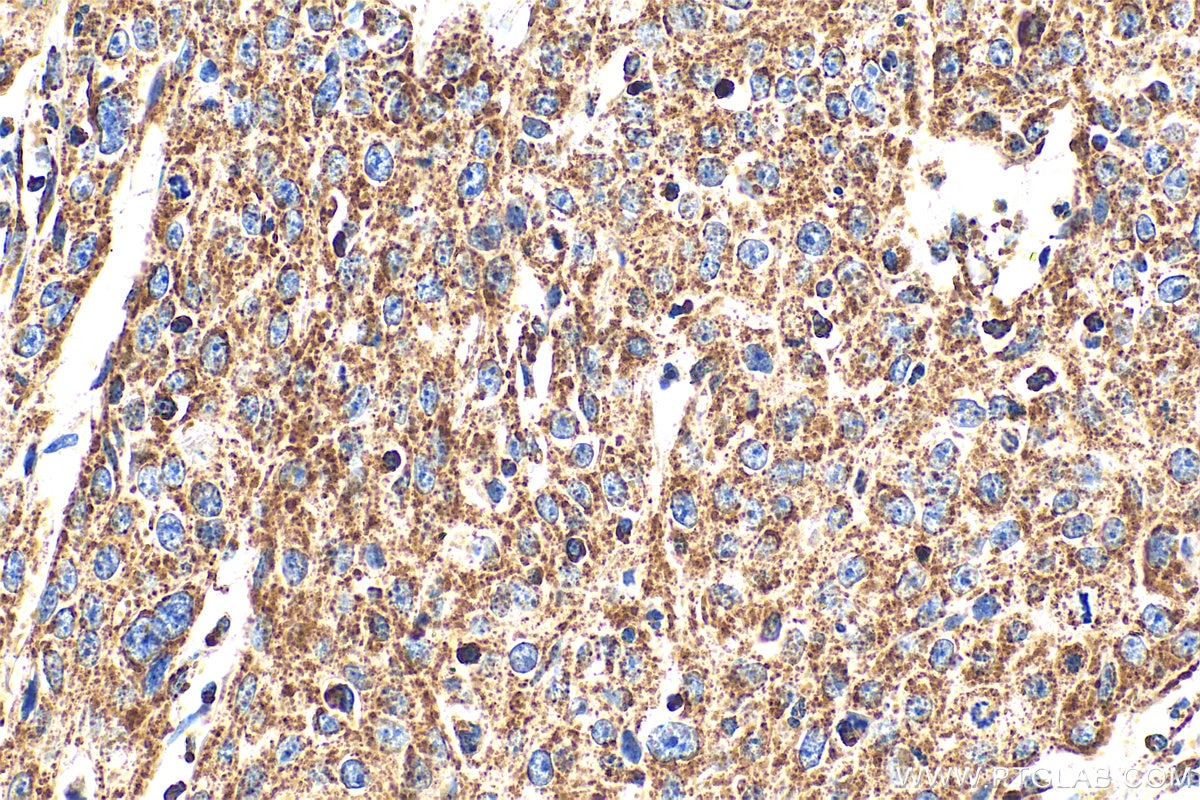
Immunohistochemical analysis of paraffin-embedded human cervical cancer tissue slide using 30663-1-AP (C6orf57 antibody) at dilution of 1:200 (under 40x lens). Heat mediated antigen retrieval with Tris-EDTA buffer (pH 9.0). Immunohistochemistry (IHC) staining of human cervical cancer tissue using SDHAF4 Polyclonal antibody (30663-1-AP)

Tested Applications
| Positive IP detected in | THP-1 cells |
| Positive IHC detected in | human cervical cancer tissue, human breast cancer tissue Note: suggested antigen retrieval with TE buffer pH 9.0; (*) Alternatively, antigen retrieval may be performed with citrate buffer pH 6.0 |
| Positive IF/ICC detected in | A431 cells, U2OS cells |
Recommended dilution
| Application | Dilution |
|---|---|
| Immunoprecipitation (IP) | IP : 0.5-4.0 ug for 1.0-3.0 mg of total protein lysate |
| Immunohistochemistry (IHC) | IHC : 1:50-1:500 |
| Immunofluorescence (IF)/ICC | IF/ICC : 1:200-1:800 |
| It is recommended that this reagent should be titrated in each testing system to obtain optimal results. | |
| Sample-dependent, Check data in validation data gallery. | |
Product Information
30663-1-AP targets SDHAF4 in IHC, IF/ICC, IP, ELISA applications and shows reactivity with human samples.
| Tested Reactivity | human |
| Host / Isotype | Rabbit / IgG |
| Class | Polyclonal |
| Type | Antibody |
| Immunogen |
CatNo: Ag33549 Product name: Recombinant human C6orf57 protein Source: e coli.-derived, PGEX-4T Tag: GST Domain: 21-108 aa of BC104649 Sequence: ARSPLLCHSLRKTSSSQGGKSELVKQSLKKPKLPEGRFDAPEDSHLEKEPLEKFPDDVNPVTKEKGGPRGPEPTRYGDWERKGRCIDF Predict reactive species |
| Full Name | chromosome 6 open reading frame 57 |
| Observed Molecular Weight | 15 kDa |
| GenBank Accession Number | BC104649 |
| Gene Symbol | C6orf57 |
| Gene ID (NCBI) | 135154 |
| RRID | AB_3742363 |
| Conjugate | Unconjugated |
| Form | Liquid |
| Purification Method | Antigen affinity purification |
| UNIPROT ID | Q5VUM1 |
| Storage Buffer | PBS with 0.02% sodium azide and 50% glycerol, pH 7.3. |
| Storage Conditions | Store at -20°C. Stable for one year after shipment. Aliquoting is unnecessary for -20oC storage. 20ul sizes contain 0.1% BSA. |
Background Information
SDHAF4 (Succinate Dehydrogenase Assembly Factor 4) is a key mitochondrial protein specifically responsible for assisting in the assembly and stability of mitochondrial complex II (Succinate Dehydrogenase, SDH). This complex plays a central role in cellular energy metabolism by participating simultaneously in the tricarboxylic acid (TCA) cycle and the electron transport chain. Its function involves binding to the SDHA (flavoprotein) subunit, which is already associated with FAD, thereby preventing excessive ROS generation. It further promotes the assembly of SDHA with the iron-sulfur protein SDHB to form the catalytic dimer. This ensures the proper integration of complex II into the inner mitochondrial membrane, allowing it to participate in both the TCA cycle and electron transport. Deficiency of SDHAF4 leads to reduced SDH activity, accumulation of succinate, and elevated mitochondrial superoxide levels, which are associated with certain cardiomyopathies and tumor metabolic reprogramming.
Protocols
| Product Specific Protocols | |
|---|---|
| IF protocol for SDHAF4 antibody 30663-1-AP | Download protocol |
| IHC protocol for SDHAF4 antibody 30663-1-AP | Download protocol |
| IP protocol for SDHAF4 antibody 30663-1-AP | Download protocol |
| Standard Protocols | |
|---|---|
| Click here to view our Standard Protocols |